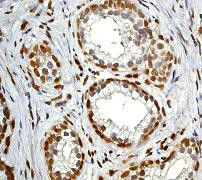

> Antigen, Antibodies, ELISA, Western Blot > Primary Antibody > Monoclonal Antibodies > Stat-3 Antibody Phospho (pY705)Brand |
Leading Biology | Catalog Number |
APR11192G |
Product Type |
Monoclonal Antibodies | Field of Research |
|
Product Overview |
We constantly strive to ensure we provide our customers with the best antibodies. As a result of this work we offer this antibody in purified format.
We are in the process of updating our datasheets. If you have any questions regarding this update, please feel free to contact our technical support team.
This product is a high quality Stat-3 antibody Phospho (pY705).
|
||
Molecular Weight |
88068 Da
|
||
Cellular Localization |
Antigen Cellular Localization:
Cytoplasm. Nucleus. Note=Shuttles between the nucleus and the cytoplasm. Translocated into the nucleus upon tyrosine phosphorylation and dimerization, in response to signaling by activated FGFR1, FGFR2, FGFR3 or FGFR4. Constitutive nuclear presence is independent of tyrosine phosphorylation Predominantly present in the cytoplasm without stimuli. Upon leukemia inhibitory factor (LIF) stimulation, accumulates in the nucleus. The complex composed of BART and ARL2 plays an important role in the nuclear translocation and retention of STAT3 Identified in a complex with LYN and PAG1
|
||
Host |
Rabbit
|
||
Species Reactivity |
Human, Mouse
|
||
Target |
A synthetic phospho-peptide corresponding to residues surrounding tyrosine 705 of human Stat3 was used as immunogen.
|
||
Clone |
EP2147Y
|
||
Symbol |
APRF
|
||
GeneID |
|||
UniProt ID |
|||
Function |
Signal transducer and transcription activator that mediates cellular responses to interleukins, KITLG/SCF and other growth factors. May mediate cellular responses to activated FGFR1, FGFR2, FGFR3 and FGFR4. Binds to the interleukin-6 (IL-6)- responsive elements identified in the promoters of various acute- phase protein genes. Activated by IL31 through IL31RA. Cytoplasmic STAT3 represses macroautophagy by inhibiting EIF2AK2/PKR activity. Plays an important role in host defense in methicillin-resistant S.aureus lung infection by regulating the expression of the antimicrobial lectin REG3G (By similarity).
|
||
Summary |
Stat3 is a member of a group of proteins (Signal Transduction and Activators of Transcription) that act as both signal transducers for cytokines and growth factors, as well as transcription factors (1,2). Stats are activated by tyrosine phosphorylation in response to different ligands, after which they translocate to the cell nucleus (1). Stat3 is constitutively activated in a number of human tumors (3). Stat3 is activated by phosphorylation on tyrosine 705 which induces dimerization, nuclear translocation, and DNA binding Meanwhile, Stat3-activated transcription seems to be regulated by serine phosphorylation at serine 727 (4).
|
||
Form |
50 mM Tris-Glycine (pH 7.4), 0.15 M NaCl, 40% Glycerol, 0.01% sodium azide and 0.05% BSA. |
||
Storage & Stability |
Store at +4°C short term. For long-term storage, aliquot and store at -20°C or below. Stable for 12 months at -20°C. Avoid repeated freeze-thaw cycles.
|
||
Applications |
WB, IHC, IF
|
||
Dilution |
WB~~1:10000~20000
IHC~~1:100~250
|
||
Synonyms |
Signal transducer and activator of transcription 3, Acute-phase response factor, STAT3, APRF
|
||
Images |

A. Western blot analysis on HeLa cell lysates using anti-Phospho-Stat3 (pY705) RabMAb (Cat. APR11192G), 1:20,000 dilution. Cells were either (A) untreated (B) treated with IFN-alpha.
B. Immunohistochemical analysis of paraffin-embedded human colon adenocarcinoma using anti-Phospho STAT3 (pY705) RabMAb (Cat. APR11192G). 
C. Immunofluorescent staining of HeLa cells using anti-Phospho STAT3 (pY705) RabMAb (Cat. APR11192G) |
||
Specification |
|||
Quantity |
|
||
| Select | Brand | Catalog No. | Product Name | Pack Size | Type | Field of Research | Specification | Quantity | Price(USD) | |
| 1 | Leading Biology | APG02467G | CCK4 / PTK7 Antibody (clone 4F9) | 50 μl | Monoclonal Antibodies |
|
$495.00 | Add Ask | ||
| 2 | Leading Biology | AMM04683G | GALT Antibody (clone 4C11) | 50 μg | Monoclonal Antibodies |
|
$545.00 | Add Ask | ||
| 3 | Leading Biology | AMM01402G | Vimentin (Mesenchymal Cell Marker) Antibody - With BSA and Azide | 50 ug | Monoclonal Antibodies |
|
$395.00 | Add Ask | ||
| 4 | Leading Biology | APR08280G | LTA4H / LTA4 Antibody (clone 9G8) | 50 μl | Monoclonal Antibodies |
|
$495.00 | Add Ask | ||
| 5 | Leading Biology | AMM00172G | CD1a / HTA1 (Mature Langerhans Cells Marker) Antibody - With BSA and Azide | 50 ug | Monoclonal Antibodies |
|
$395.00 | Add Ask | ||
| 6 | Leading Biology | AMM05750G | CEBPA Antibody | 100 μl | Monoclonal Antibodies |
|
$545.00 | Add Ask |
 Leading Biology Inc.
2600 Hilltop DR, Building G, B Suite C138
Richmond, CA, 94806
Tel: 1-661-524(LBI)-0262
Email: info@leadingbiology.com
Leading Biology Inc.
2600 Hilltop DR, Building G, B Suite C138
Richmond, CA, 94806
Tel: 1-661-524(LBI)-0262
Email: info@leadingbiology.com
Complete this form and click send to ask us a question, request a quote or simply say hello.

You have 0 item in your cart

You have 0 item in your inquiry list
